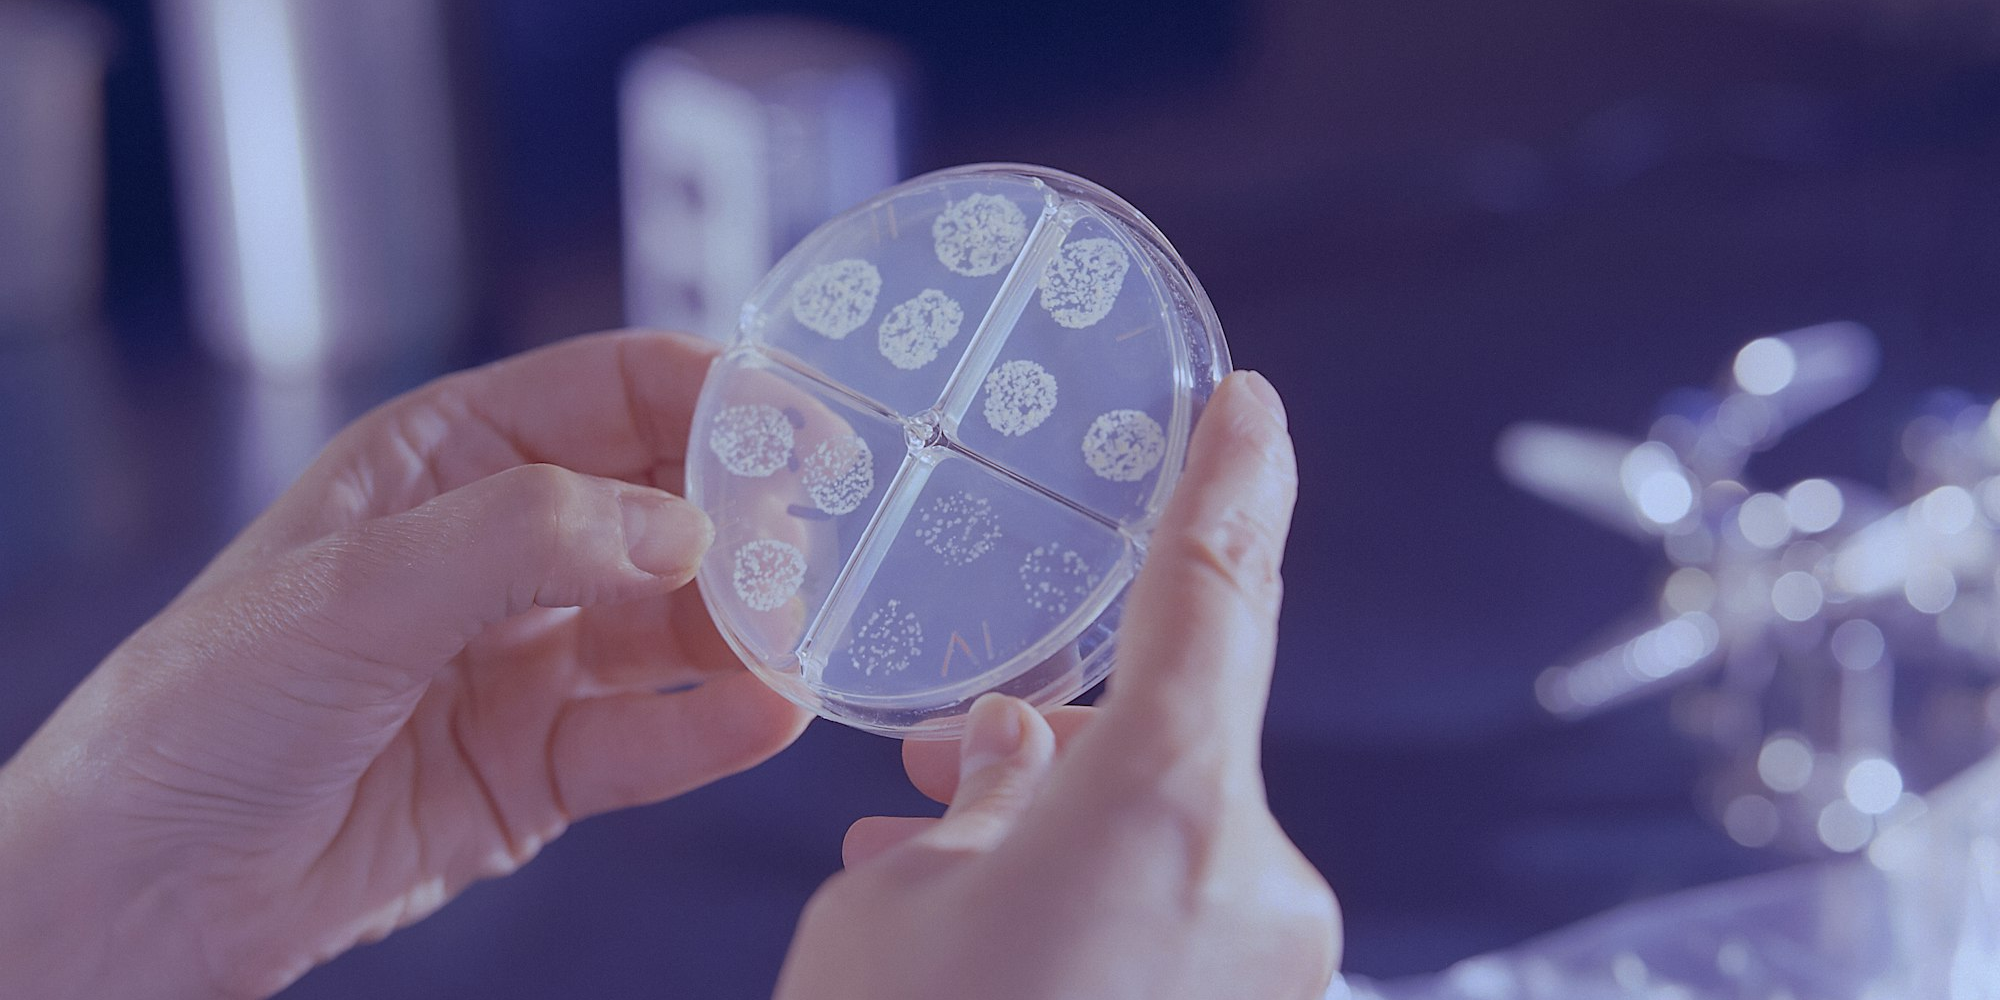
Кабмин утвердил перечень работ, запрещенных для лиц с риском распространения туберкулеза

Кабмин утвердил перечень работ, запрещенных для лиц с риском распространения туберкулеза
На основании части 4 статьи 49 закона КР «Об общественном здравоохранении», а также статей 13 и 17 закона «О кабинете министров», правительство утвердило перечень работ, запрещенных для лиц, создающих риск распространения туберкулеза.
Полный список работ содержится в приложении к документу. В его предварительной версии на этапе рассмотрения инициативы в августе 2024 года в перечень были включены:
- предприятия пищевых отраслей промышленности, общественного питания, пищеблоков всех учреждений, буфетов, кафе, ресторанов, молочных кухонь, торговли, баз, складов, имеющих контакт с продуктами питания в процессе их производства, хранения, реализации и транспортировки на всех видах транспорта;
- работники в сфере обслуживания пассажиров общественного транспорта (проводники пассажирских поездов, бортпроводники авиатранспорта, бортпроводники прогулочных теплоходов).;
- служба доставки питания;
- хирургические подразделения всех профилей, операционные, анестезиология, операционные блоки, стоматология, отоларингология;
- медицинские учреждения, независимо от форм собственности, родильные дома (отделения), детские больницы (отделения);
- вузы, учебно-воспитательные учреждения (общеобразовательные школы, школы-интернаты, средние специальные учебные учреждения и другие), детские и подростковые спортивные, лечебно-оздоровительные учреждения, библиотеки, детские библиотеки;
- детские дошкольные учреждение (детские сады, дома ребенка, детские дома);
- аптеки, фармацевтические заводы, фирмы, занятые изготовлением, расфасовкой и реализацией лекарственных средств;
- государственные и частные бани, бассейны, лечебные ванны, прачечные, общежития, гостиницы, хостелы;
- парикмахерские, косметологические салоны, салоны красоты;
- работники спортивно-оздоровительных учреждении независимо от формы собственности (спортзалы, фитнес-клубы, спортивные базы);
- организации водопроводных сооружений и водопроводных сетей.




